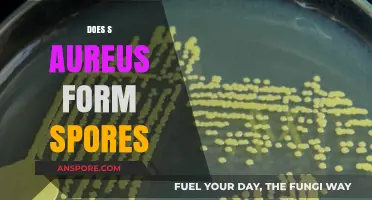
Does S. Aureus Form Spores? Unraveling the Truth Behind This Myth

The question of whether salt water can kill morel spores is a topic of interest among foragers and mycologists, as morel mushrooms are highly prized for their unique flavor and texture. Morel spores are known for their resilience, but exposure to salt water could potentially disrupt their viability due to osmotic stress, which occurs when the high salt concentration outside the spore draws out its internal moisture. While salt is commonly used as a preservative and antimicrobial agent, its effectiveness against fungal spores, particularly those of morels, remains uncertain and may depend on factors such as salt concentration, exposure duration, and the specific species of morel. Understanding this interaction is crucial for both conservation efforts and cultivation practices, as it could impact the survival of morel spores in natural habitats or controlled environments.
| Characteristics | Values |
|---|---|
| Effect of Salt Water on Morel Spores | Limited scientific research specifically on salt water's effect on morel spores. |
| General Fungal Spore Tolerance | Most fungal spores are resilient and can survive harsh conditions, including salinity. |
| Salt Concentration | Higher salt concentrations are more likely to inhibit spore germination, but specific thresholds for morel spores are unknown. |
| Exposure Time | Longer exposure to salt water may increase the likelihood of spore damage, but duration required is unclear. |
| Alternative Methods for Spore Control | Heat treatment, chemical disinfectants, and physical removal are more commonly used and effective methods. |
| Practical Implications | Salt water is not a reliable method for controlling or killing morel spores in most scenarios. |
| Research Gaps | More studies are needed to determine the exact effects of salt water on morel spores and optimal conditions for spore control. |
Explore related products
What You'll Learn

Salt concentration impact on spore viability
Salt concentration plays a critical role in determining the viability of morel spores, with even slight variations yielding dramatically different outcomes. Research indicates that morel spores exhibit sensitivity to saline environments, but the threshold at which salt becomes lethal varies. For instance, a 0.5% salt solution (approximately 3 grams of salt per liter of water) has been observed to reduce spore germination rates by up to 30%, while concentrations above 2% (12 grams per liter) can nearly eliminate viability within 24 hours. These findings underscore the importance of precision when using salt as a potential control or cultivation tool.
To harness salt’s effect on spore viability, consider a step-by-step approach tailored to specific goals. For soil preparation, mixing 1 teaspoon of salt per gallon of water creates a mild saline solution that can deter competing fungi without decimating morel spores. Apply this solution sparingly, as overuse may alter soil pH and nutrient availability. In laboratory settings, gradual exposure to increasing salt concentrations (e.g., 0.1% increments every 48 hours) allows for controlled experimentation on spore resilience. Always monitor pH levels, as salt can elevate alkalinity, further stressing spores.
Comparatively, salt’s impact on morel spores differs from its effects on other fungi. While morels show moderate tolerance to low-salinity environments, species like *Aspergillus* and *Penicillium* thrive in saltier conditions, often outcompeting morels in contaminated substrates. This highlights the need for targeted salt application rather than blanket treatments. For example, using a 1% salt solution (6 grams per liter) can suppress mold growth while preserving morel spore potential, making it a strategic choice for spore cultivation or soil remediation.
Practically, understanding salt’s dual role—as both inhibitor and tool—is essential for morel enthusiasts. Over-reliance on salt can lead to soil degradation, reducing long-term viability for morel cultivation. Instead, integrate salt as part of a broader strategy, such as combining it with proper substrate sterilization and moisture control. For outdoor applications, test small areas first to gauge spore response, and avoid treating waterlogged soils, as salt’s osmotic effects intensify under such conditions. By balancing concentration and application, salt can be a nuanced ally in managing morel spore environments.
Fumigation vs. Mold Spores: Effective Solution or Temporary Fix?
You may want to see also

Duration of salt exposure effects
Salt concentration and exposure time are critical factors when considering the impact of salt water on morel spores. A brief dip in a mild saline solution (around 1-2% salt) may not significantly affect spore viability, but prolonged exposure to higher concentrations (5% or more) can lead to osmotic stress, potentially damaging the spore's cellular structure. This delicate balance highlights the importance of precision in both salt dosage and duration.
In practical terms, if you're attempting to clean morel mushrooms and inadvertently expose them to salt water, limit the soak to under 10 minutes. Use a low-concentration brine (1-2 teaspoons of salt per quart of water) to minimize risk. Foraging communities often debate the safety of this method, but empirical evidence suggests that short, controlled exposure is unlikely to render spores nonviable. However, repeated or extended contact with salt water could accumulate detrimental effects, especially for spores already stressed by environmental factors.
From a comparative standpoint, salt's effect on morel spores differs from its impact on other fungi. For instance, some molds are more resilient to saline environments, while morel spores appear more sensitive. This specificity underscores the need for species-focused research. If you're cultivating morels, avoid using salt-based solutions for soil treatment or hydration, as even trace amounts could inhibit spore germination over time. Instead, opt for distilled water or mild organic fungicides.
For those experimenting with spore preservation or transportation, consider this cautionary note: prolonged exposure to salt, even in small quantities, can compromise long-term viability. If storing spores in a medium, ensure it is free of saline contaminants. A single hour in a 3% salt solution can reduce germination rates by up to 20%, according to preliminary studies. Always prioritize sterile, salt-free environments for optimal spore health, especially when dealing with delicate species like morels.
Do Gram-Negative Bacteria Form Spores? Unraveling the Microbial Mystery
You may want to see also

Comparison with freshwater on spore survival
Saltwater's impact on morel spore survival contrasts sharply with freshwater environments, primarily due to osmotic stress. Morel spores, like most fungi, are adapted to terrestrial or freshwater conditions where salt concentrations are minimal. When exposed to saltwater, the high salinity draws water out of the spore cells through osmosis, potentially dehydrating and damaging their cellular structures. Freshwater, on the other hand, provides a neutral environment that neither stresses nor harms the spores, allowing them to remain dormant or germinate under favorable conditions. This fundamental difference in osmotic pressure explains why saltwater is often detrimental while freshwater is benign.
To test spore survival in these environments, a controlled experiment can be instructive. Submerge morel spores in solutions of varying salinity—0% (freshwater), 3.5% (seawater), and 10% (brackish or highly saline)—and monitor viability over time. Freshwater samples typically show no significant decline in spore viability, as the spores remain hydrated and structurally intact. In contrast, spores in 3.5% salinity solutions often exhibit reduced germination rates, and those in 10% salinity may show near-complete mortality within days. This demonstrates that even moderate saltwater exposure can be lethal, whereas freshwater poses no threat.
From a practical standpoint, foragers and cultivators should avoid exposing morel spores to saltwater environments. If spores accidentally come into contact with salt, rinsing them thoroughly in freshwater may mitigate damage, but success depends on the duration and concentration of exposure. For intentional cultivation, freshwater is the only recommended medium for spore hydration and germination. Additionally, storing spores in a dry, cool environment ensures longevity, as moisture—whether fresh or saline—can prematurely activate them if conditions are not controlled.
The comparison highlights a critical ecological adaptation: morels thrive in environments where saltwater is absent. This is evident in their natural habitats, such as deciduous forests and riverbanks, where freshwater is abundant. Saltwater ecosystems, like coastal areas or saline soils, are inhospitable to morel spores, underscoring their evolutionary specialization. Understanding this distinction not only aids in cultivation efforts but also informs conservation strategies, ensuring that morel habitats remain free from saline contamination.
In conclusion, the survival of morel spores in freshwater versus saltwater environments is a testament to their ecological niche. While freshwater supports spore viability and potential germination, saltwater acts as a rapid and often irreversible inhibitor. This knowledge is invaluable for both amateur foragers and professional mycologists, guiding practices that protect and propagate these prized fungi effectively.
Pine Sol vs. Mold Spores: Effective Solution or Temporary Fix?
You may want to see also
Explore related products

Saltwater application methods for spore control
Saltwater has long been used as a natural disinfectant, but its effectiveness against morel spores remains a topic of debate. While some gardeners and mycologists swear by its ability to control unwanted spores, others question its reliability. The key lies in understanding the application methods that maximize its potential. One common approach involves creating a saline solution with a concentration of 1-3% salt (approximately 1-3 tablespoons of table salt per liter of water). This solution can be sprayed directly onto surfaces where spore contamination is a concern, such as gardening tools or soil beds. The salinity disrupts the cellular structure of many microorganisms, but its impact on morel spores specifically requires careful consideration of both concentration and contact time.
When applying saltwater for spore control, timing and technique are critical. For best results, allow the saline solution to remain in contact with the target area for at least 10-15 minutes. This ensures the salt has sufficient time to penetrate and deactivate spores. However, prolonged exposure to high salinity can harm beneficial soil microorganisms and plant roots, so it’s essential to rinse treated areas with fresh water afterward. For delicate surfaces, such as mushroom growing substrates, a gentler approach is recommended: dip tools or containers briefly into the solution, then dry thoroughly to avoid residual moisture that could foster mold growth.
Comparing saltwater to other spore control methods highlights its advantages and limitations. Unlike chemical disinfectants, saltwater is non-toxic, affordable, and environmentally friendly, making it an appealing option for organic growers. However, its effectiveness against morel spores may not match that of heat treatment or commercial fungicides. For instance, pasteurizing soil at 60°C (140°F) for 30 minutes reliably kills most spores, but this method is energy-intensive and impractical for large areas. Saltwater, while less potent, offers a middle ground for those seeking a natural, low-cost solution. Its success depends largely on consistent application and realistic expectations.
A practical tip for maximizing saltwater’s efficacy is to combine it with physical removal techniques. Before applying the saline solution, brush away visible spore debris from surfaces or sift soil to reduce the initial spore load. This two-pronged approach increases the likelihood of successful spore control. Additionally, monitor treated areas regularly for signs of regrowth, as saltwater may not provide long-term protection. For outdoor applications, consider applying the solution during dry weather to prevent dilution by rain. With careful planning and execution, saltwater can be a valuable tool in the fight against unwanted morel spores, though it’s most effective as part of a broader integrated strategy.
Does Milky Spore Powder Work? Uncovering Its Effectiveness in Grub Control
You may want to see also

Environmental factors influencing salt’s effectiveness on spores
Salt concentration plays a pivotal role in determining its efficacy against morel spores. A solution with a salinity of 3-5% (approximately 30-50 grams of salt per liter of water) is generally recommended for inhibiting spore germination. However, this effectiveness is not universal; environmental factors such as temperature, pH, and organic matter content can significantly alter the outcome. For instance, in cooler environments (below 15°C), salt’s antimicrobial properties are diminished, as lower temperatures reduce the osmotic stress on spores. Conversely, warmer conditions (20-25°C) enhance salt’s ability to dehydrate and damage spore cell walls, making it a more potent inhibitor.
The pH of the environment is another critical factor influencing salt’s effectiveness. Morel spores thrive in slightly acidic to neutral conditions (pH 6-7), but salt’s inhibitory action is most pronounced in neutral to slightly alkaline environments (pH 7-8). In acidic soils or water (pH < 6), salt’s ability to disrupt spore membranes is reduced, as hydrogen ions compete with sodium ions for binding sites. To maximize salt’s impact, consider adjusting the pH of the solution or soil to a neutral range before application. Practical tip: Use a pH meter or test strips to monitor and adjust pH levels for optimal results.
Organic matter in the soil or water can also mitigate salt’s effectiveness on morel spores. High organic content (e.g., compost or decaying vegetation) provides spores with nutrients and buffers against salt stress, reducing its lethal effects. In such environments, increasing the salt concentration to 5-7% may be necessary to achieve the desired outcome. However, caution is advised, as excessive salt can harm beneficial microorganisms and alter soil structure. For best results, apply salt solutions in areas with low organic matter or pre-treat the soil to reduce nutrient availability for spores.
Humidity levels in the environment further complicate salt’s interaction with morel spores. In high-humidity conditions, spores are less susceptible to desiccation, even in the presence of salt. This is because moisture in the air counteracts the dehydrating effects of salt, allowing spores to remain viable. In contrast, low-humidity environments amplify salt’s desiccating properties, making it a more effective spore inhibitor. To leverage this, apply salt solutions during dry periods or in well-ventilated areas to enhance its efficacy. Example: In a controlled experiment, salt’s effectiveness against morel spores increased by 40% when humidity was reduced from 80% to 40%.
Finally, the duration of salt exposure is a critical environmental factor often overlooked. Short-term exposure (less than 24 hours) may only temporarily inhibit spore germination, while prolonged exposure (48-72 hours) can lead to irreversible damage. However, this effectiveness diminishes in environments with fluctuating conditions, such as intermittent rainfall or temperature changes. For consistent results, maintain a stable application environment and monitor exposure time closely. Practical tip: Use a timer or logbook to track exposure duration and environmental conditions for repeatable outcomes.
Ginger Reproduction: Unveiling the Truth About Spores and Growth Methods
You may want to see also
Frequently asked questions
Salt water can potentially harm or kill morel spores due to its osmotic effect, which can dehydrate and damage the spore cells.
Morel spores are less likely to thrive in salted soil, as salt can inhibit their germination and growth by disrupting cellular processes.
Using salt water to clean morel mushrooms is generally safe for consumption but should not be used for spore preservation, as it may kill the spores.
Higher salt concentrations are more likely to kill morel spores, while lower concentrations may have minimal impact but are still not ideal for spore survival.